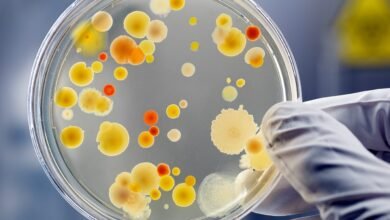
Bacteria listeria

Вспышки гепатита А и норовируса в Ирландии связывают с импортными замороженными ягодами

Эксперты в области здравоохранения вынесли предупреждение об опасности всем, кто использует замороженные ягоды в смузи или коктейлях, так как с их употреблением связывают вспышки гепатита А и норовируса в Ирландии.
Центр охраны здоровья (The Health Protection Surveillance Centre) предупредил общественность об опасности, связанной с употреблением импортных замороженных ягод, если они предварительно не обработаны термически.
Рекомендация HPSC: замороженные ягоды нужно варить в кипящей воде не менее одной минуты перед употреблением.
Представитель HPSC сказал: «С началом летнего сезона мы хотели бы напомнить потребителям о текущем совете Управления по безопасности пищевых продуктов (FSAI): мыть свежие ягоды и варить замороженные ягоды одну минуту до употребления».
«В последние годы в Ирландии и Европе были вспышки гепатита А и норовируса, связанные с импортом замороженных ягод».
«Крупнейшей из них была продолжительная вспышка гепатита А, с 2013 по 2014 год, поразившая более 1500 человек в 13 странах ЕС/ЕЭЗ, включая Ирландию».
«После этого в Европе были зарегистрированы небольшие вспышки гепатита А, связанные с импортированными замороженными ягодами, в том числе одна в Швеции и Австрии прошлым летом и одна в Нидерландах в 2017 году».
По информации из Управления по безопасности пищевых продуктов в Ирландии, ягоды могут быть заражены на ферме из-за использования сточных вод в сельском хозяйстве или из-за заражения рабочих.
Загрязнение также может произойти в результате контакта с загрязненными поверхностями машин и оборудования во время процессов замораживания, смешивания и упаковки.
Вот все, что вам нужно знать о гепатите А и норовирусе.
Что такое гепатит А и каковы симптомы?
Гепатит А — это острое заболевание печени, вызванное вирусом гепатита А. Существует пять основных вирусов гепатита, которые называются типами A, B, C, D и E.
Болезнь обычно начинается примерно через 28 дней после заражения вирусом, но может начаться в любое время между 15 и 50 днями после заражения. Наиболее распространенными симптомами являются высокая температура, потеря аппетита, тошнота, усталость и боль в животе, сопровождаемая в течение нескольких дней желтухой.
Болезнь часто не имеет заметных симптомов или проявляется в легкой форме, особенно у детей младше пяти лет. Желтуха встречается у 70-80% людей в возрасте старше 14 лет и менее чем у 10% детей младше шести лет.
Симптомы могут длиться от одной или двух недель до нескольких месяцев. Длительный рецидивирующий гепатит на срок до одного года встречается в 15% случаев.
Что делать, если мне кажется, что у меня гепатит А?
Вам следует обратиться к врачу. Более подробную информацию о гепатите А можно найти на сайте Центра охраны здоровья (HPSC).
Как распространяется вирус гепатита А?
Гепатит А — это вирус человека, который в основном распространяется от человека к человеку через фекально-оральный путь.
Он также может распространяться через пищу, которая была заражена поставщиками пищи или загрязненной водой. Люди, у которых есть вирус, наиболее заразны за неделю или две до появления симптомов и могут быть заразны до одной недели после появления болезни.
Что такое норовирус и каковы симптомы?
Норовирус является одной из наиболее распространенных причин гастроэнтерита. Симптомы включают — тошноту, рвоту и диарею. Симптомы начинаются примерно через 12-48 часов после заражения.
Болезнь обычно непродолжительна, большинство людей полностью выздоравливают в течение одного-двух дней, однако некоторые больные (обычно дети или пожилые люди) могут нуждаться в стационарном лечении.
Что делать, если мне кажется, что у меня есть норовирус?
Вам следует обратиться к врачу. Более подробную информацию о норовирусе можно найти на сайте Центра охраны здоровья (HPSC).
Как распространяется норовирус?
Норовирусы очень заразны и могут легко передаваться от человека к человеку. Фекалии и рвота инфицированного человека содержат вирус и являются заразными.
Люди, инфицированные норовирусом, заразны с того момента, как только начинают чувствовать себя плохо и до двух-трех дней после выздоровления. Некоторые люди могут быть заразными в течение двух недель после выздоровления.
Важно тщательно мыть руки и соблюдать гигиену, если человек недавно переболел норовирусной инфекцией. Кроме того, норовирусы очень устойчивы и могут выживать в окружающей среде (например, на поверхностях) в течение нескольких недель.
Для получения дополнительной информации посетите сайт Управления по безопасности пищевых продуктов (FSAI).
Источник: https://www.irishmirror.ie/
В Ирландии самый низкий уровень заболеваемости Covid-19 в Западной Европе
Подписывайтесь на официальную страницу сайта в Facebook.
Подписывайтесь на наш канал в Telegram, чтобы быть в курсе всех новостей — https://t.me/newsruie или читайте все новости в удобном формате прямо с экрана вашего компьютера или планшета — https://t.me/s/newsruie